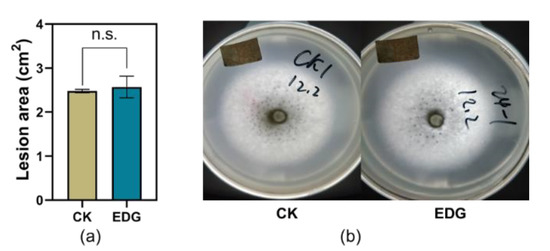

Abstract
Jasmonates (JAs), the group of lipid-derived hormones, were found to control the defense responses in a myriad of plants. Meaningfully, the macrolactones of 12-hydroxy jasmonate isoleucine (12OH-JA-Ile) were reported to induce the defensive response of wild tobacco. However, little to nothing has been known about the elicitation effect of JA-Ile-macrolactones on woody plants to harmful organisms, let alone its underlying mechanisms. Here, we first optimized the synthetic routine using mild toxic reagent isobutyl chloroformate instead of ethyl chloroformate for conjugation, and we used acetonitrile (MeCN) instead of ethyl alcohol for the better dissolution of p-toluenesulfonic acid (p-TsOH) to gain JA-Ile-macrolactones. JA-Ile-macrolactone 5b-treated tea plants significantly inhibited the larvae weight gain of Ectropis obliqua larvae and the lesions caused by Colletotrichum camelliae. Furthermore, the expression level of CsOPR3 was significantly upregulated in 5b-treated leaves. Meanwhile, 5b reduced the accumulation of eriodictyol 7-O-glucuronide (EDG) in tea plants, which was confirmed to promote the growth rate of E. obliqua larvae by artificial diet assay. In conclusion, our study proved that the exogenous application of 5b could induce the tea plant resistance both to herbivore E. obliqua and pathogen C. camelliae, and EDG was identified as one of the secondary metabolites that could influence the growth rate of E. obliqua, but it did not directly influence the infection of C. camelliae in vitro. Further research should be carried out to clarify the mechanism through which 5b induces tea plant resistance to C. camelliae.
1. Introduction
During the hundreds of millions of years of evolution with herbivores and pathogens, plants have acquired sophisticated strategies to defense against them [1], such as producing direct toxic and anti-nutritional compounds to hinder insect growth or pathogen infection, or emitting volatiles to attract natural enemies of herbivorous pests [2]. Accumulated lines have revealed that these plant defense responses are often initiated upon recognizing herbivore/pathogen-derived cues or chemical regulators, followed by the activation of defense-related phytohormone signaling pathways, such as jasmonic acid (JA), salicylic acid (SA), ethylene (ET), etc., to mediate specific defense responses [3]. Therefore, more evidence demonstrated that the exogenous application of phytohormones could elicit plant resistance against herbivores or pathogens either in herbs or in woody plants [4]. In recent years, the analogues of these phytohormones modulating the corresponding pathways have been investigated by researchers [5,6]. Several chemical elicitors have been commercially used in greenhouse disease control, such as benzo (1,2,3)-thiadiazole-7-carbothioic acid S-methyl ester (BTH), 2,6-dichloroisonicotinic acid (INA), β-aminobutyric acid (BABA), tiadinil (TDL), and pyraclostrobin [7,8,9,10,11]. Numerous chemical elicitors have been found to trigger direct or indirect plant-induced defense responses against herbivores in the laboratory, such as methyl jasmonate (MeJA), coronalon, laminarin, and so on [12,13,14,15]. Moreover, 2, 4-dichlorophenoxyacetic acid [16], JA, and cis-jasmone [17] have been verified to elevate the plant defense capability against herbivores in the field, which is an attractive prospect for pest controlling [18,19]. Unfortunately, no any chemical elicitor has been used commercially in pest control until now.
Jasmonates (JAs), a large family of lipid-derived plant hormones, play a dominant role in modulating the plant response to stresses [20,21,22,23]. Biotic attack or mechanical injury induce the synthesis and accumulation of JA [20]. After the perception of (+)-7-iso-Jasmonoyl-L-isoleucine (JA-Ile) by receptor CORONATINE INSENSITIVE 1 (COI1), transcriptional repressor JASMONATE ZIM-DOMAIN (JAZ) proteins would be degraded [24]. Then, the expression of genes, all the major classes of secondary metabolites, and proteins related with immunity and defense are induced. The exogenous application of JAs could induce the morphological and physiological responses of plants [25]. For instance, MeJA enhanced the resistance of Arabidopsis thaliana to both cabbage looper Trichoplusia ni and pathogen Pseudomonas syringae pv tomato [26,27]. Moreover, other JAs with biological activity including a lot of structural analogues of JA-Ile from nature and chemical synthesis have been reported continuously [28,29,30,31,32,33]. The conjugates of JA with L-leucine and L-valine that occur in nature have been found to upregulate the transcript accumulation of JA-responsive genes, but still a series of the synthetic modification of JA had not exhibited biological activity in the modulation of plant defenses [29]. The phytotoxin coronatine, a structural mimic of JA-Ile produced by the plant pathogen P. syringae [30], is considerably more active than JA-Ile in promoting the interaction of the COI1 receptor with the JAZ repressors in vitro [24]. Moreover, the two products of lactonization of 12-OH-JA-Ile were found to induce the defensive responses of wild tobacco Nicotiana tabacum against Manduca sexta [32,33]. Nevertheless, little to nothing has been known about the elicitation effect of JA-Ile-macrolactones on woody plants to harmful organisms, let alone its underlying mechanisms.
Chemical pesticides are still an efficient approach to control pests and pathogens in the agriculture, which have caused serious “3R” problems (resistance, resurgence, and residence) [34]. The tea plant, Camellia sinensis, is one of the most important woody-plantation crops in the world. Developing tea shoots and leaves are the raw material for commercial tea, while they often suffer damages from numerous harmful organisms, such as the tea geometrid (TG) Ectropis obliqua, one of the main leaf-feeding pests of tea plantation in China, and Colletotrichum camelliae, one of the dominant leaf diseases that usually causes anthracnose disease leading to plant wilt, shoot death, and fragility [35,36,37]. Previous results showed that TG caterpillars developed more slowly on JA-treated tea plants than on control plants, and the larvae weight gain depended on the JA dosage and their infestation time [38]. Furthermore, a series of genes of the JA signaling pathway such as 12-oxophytodienoate reductase 3 (CsOPR3), hydroperoxide lyase (CsHPL), Acyl-CoA oxidase (CsACX1, 3), polyphenol oxidases (CsPPO1, 2), and lipoxygenase (CsLOX) were found to be upregulated by the infestation of TG [14,39,40,41,42]. Further investigation verified that the JA pathway plays a central role in tea plant defense against TG [43]. JA-Ile-macrolactones are the modification of JA-Ile; whether they could elicit tea plant resistance against harmful organisms or not needs to be verified.
In the present study, the synthetic route of the two macrolactones was optimized based on the previous reports firstly [33,44]. Secondly, the effects of macrolactones on the larvae weight gain of E. obliqua and the lesions caused by C. camelliae were measured. Thirdly, the potential mechanisms were explored preliminarily through the comparison of transcription expression levels of CsOPR3 and the contents of 12 potential defensive flavonoids between control leaves and macrolactones-treated leaves. Finally, the effects of differential substance(s) on the larvae weight gain of TG caterpillars and the infection of C. camelliae were investigated.
2. Results
2.1. Optimized Synthesis of JA-Ile-Macrolactones
The synthesis began with the commercially available MeJA. 12-OH-jasmonic acid 3 was obtined through olefin metathesis catalyzed by Grubbs Z-Catalyst and saponification. Then, 3 was conjugated to L-isoleucine under alkaline condition. In this step, isobutyl chloroformate was used to replace hypertoxic ethyl chloroformate, which had been used in the reported article [33]. 4 was macrolactonized after the activation of carboxyl under acidic condition, in which p-toluenesulfonic acid (p-TsOH) was solved into acetonitrile (MeCN) to gain 5a and 5b (Scheme 1).

Scheme 1.
Optimized synthetic route of Jasmonoyl-L-isoleucine (JA-Ile)-macrolactones from Jimenez-Aleman et al. [33].
2.2. Effect of JA-Ile-Macrolactones on TG Performance
Compared with the control, JA-Ile-macrolactone 5b-treated leaves significantly reduced the larvae weight gain of TG (Figure 1). On the 8th and 10th days after the start of feeding, the weight gain of larvae that were fed on leaves treated with 5b was significantly less than those fed on controls by 32% and 47%, respectively. However, there was no significant difference between the weight gain of the larvae fed on 5a-treated tea leaves and those fed on the control leaves.

Figure 1.
Mean larvae weight gain of tea geometrid (TG) (±SE, n = 22-28) fed on JA-Ile-macrolactones-treated tea leaves. Different letters indicate significant differences among treatments (p < 0.05, Turkey’s test). The asterisk indicates significant difference between treatment and control (p < 0.05, Student’s t-test).
2.3. Effect of JA-Ile-Macrolactones on the Infection of Colletotrichum camelliae
Consistent with the effect of JA-Ile-macrolactones on TG larvae weight gain, 5b-treated tea leaves inhibited the infected area of C. camelliae in 31% compared with that in control leaves on the 4th day after the start of inoculation (Figure 2).

Figure 2.
Effect of JA-Ile-macrolactones on the infection of Colletotrichum camelliae. (a) Mean lesion area of C. camelliae on tea plants (±SE, n = 12), different letters indicate significant differences among treatments (p < 0.05, Turkey’s test); (b) Photos of the infections.
2.4. Effects of JA-Ile-Macrolactones on Transcriptional Expression Level of CsOPR3
For the accurate qRT-PCR analysis in JA-Ile-Macrolactones plus lanolin treatment, we selected and validated endogenous reference genes (RGs) at first. Ten relatively stable RGs, CsEF1, CsCLATHRIN, CsACTIN, CsGADPH, CsSAND, CsTIP, CsUBC, CsPTB, CsTUA and CsTBP, which are frequently used as stable RGs in mRNA expression analysis of tea plants [45,46,47,48], were selected as the candidates to identify the best internal RG or combination. The Ct value of these RGs under JA-Ile-macrolactones treatments were recorded for evaluating the expression of 10 RGs. As shown in Figure 3a, the lowest mean Ct value was CsGADPH (19.37) and the highest mean Ct value was CsTBP (25.00). Then, the geNorm program [49] was used to calculate the pairwise variations between two sequential normalization factors (NFn and NFn + 1) to determine the optimal number of RGs for accurate normalization. As shown in Figure 3b, the pairwise variation at the V2/3 value was below 0.15, indicating that two RGs were enough for accurate normalization.

Figure 3.
The selection and validation of endogenous reference genes. (a) Expression profiles of 10 candidate reference genes (RGs) in C. sinensis. The Ct mean value refers to the short bar; the box represents the 25th–75th percentiles, and the dark spots refer to extreme outliers; (b) Optimal number of reference genes for the normalization of C. sinensis under JA-Ile-macrolactones treatments. The pairwise variation (Vn/n + 1) was calculated by geNorm software to determine the optimal number of RGs required in the analysis of qPCR. Another RG will not significantly improve normalization when values are less than 0.15.
Based on the calculation of the four different computation programs geNorm [49], Normfinder [50], BestKeeper [51], and comparative ∆CT (Table 1), CsTBP and CsCLATHRIN were chosen as the best combination of RGs. Normalizing with the combination, the relative expression level of CsOPR3 in JA-Ile-macrolactones-treated tea leaves was significantly higher than that in the control, with 2.1-fold at 1.5 h (Figure 4).

Table 1.
Ranking of the reference genes expression under JA-Ile-macrolactones treatment.

Figure 4.
Mean relative expression level (±SE, n = 6) of CsOPR3 in tea leaves elicited by JA-Ile-macrolactones. Different letters indicate significant differences among treatments (p < 0.05, Turkey’s test). The asterisk indicates significant difference between treatment and control (p < 0.05, Student’s t-test).
2.5. The Elicitation of Flavonoids
The contents of 12 flavonoids in plants were detected (Figure 5). The accumulations of most of these metabolites were influenced by 5b, although there were no significant differences compared with the control. At 24 h, 5b significantly inhibited the accumulation of eriodictyol 7-O-glucuronide (EDG) in 26% comparing with that in control.

Figure 5.
Mean content (±SE, n = 5) of 12 flavonoids elicited by JA-Ile-macrolactones. The asterisks indicate a significant difference between treatment and control (p < 0.05, Student’s t-test).
2.6. Effects of EDG on the Performance of TG and the Infection of Colletotrichum camelliae
The larvae weight gains of TG fed on artificial diet supplemented with EDG at a concentration of 2000 ng/mL were significantly higher than those fed on control after 10 d feeding in the current study (Figure 6a,b). However, potato dextrose agar medium supplemented with EDG did not affect the infection area of C. camelliae during the testing period (Figure 7a,b).

Figure 6.
Effect of eriodictyol 7-O-glucuronide (EDG) on the performance of TG. (a) Mean larvae weight gain of TG (±SE, n = 25) fed on artificial diet supplemented with EDG in different concentrations; different letters indicate significant differences among treatments (p < 0.05, Turkey’s test); (b) Photos of their performance.
Figure 7.
Effect of EDG on the performance of C. camelliae. (a) Mean infection area of C. camelliae on potato dextrose agar medium supplemented with EDG (±SE, n = 5); n.s. indicates no significant difference between treatment and control (p > 0.05, Student’s t-test); (b) photos of the infections.
3. Discussion
Taking advantage of the plant-induced resistance against harmful organisms could be a promising alternative strategy for pests and pathogens management in the field [5,6]. A chemical elicitor is one of the most powerful tools in this domain [9,52,53,54]. Previously, several small molecule compounds have been reported to elicit tea plant resistance against herbivorous pests [14,38,55]. For example, (Z)-3-hexenol-treated [55] and JA-treated [38] tea plants inhibited the growth rate of TG larvae comparing to that of the control plants in laboratory; the β-1,3-glucan laminarin reduced the field population densities of tea green leafhopper (TLH) Empoasca (Matsumurasca) onukii Matsuda in the tea plantation [14]. Meanwhile, an interesting investigation reported that tobaccos treated with both JA-Ile-macrolactones 5a and 5b decreased the larvae mass gain and survival rate of M. sexta larvae [33]. In the present study, we firstly optimized the synthetic routine using mild toxic reagent isobutyl chloroformate instead of ethyl chloroformate for conjugation and MeCN instead of ethyl alcohol for the better dissolution of p-TsOH to gain JA-Ile-macrolactones 5a and 5b (Scheme 1), and then we investigated their induced resistance effect on tea plants. As shown in the results of this study (Figure 1), the TG larvae fed on 5b-treated tea leaves grew significantly more slowly than that on control leaves, while no significant difference of TG larvae weight gain was observed between 5a-treated leaves and controls. In addition, 5b-treated tea leaves inhibited the lesions caused by C. camelliae in 31% compared with that in control leaves (Figure 2), which meant there was an induction of defense response of tea plants that repressed the infection of C. camelliae.
OPR3 is a key member of genes encoding 12-oxophytodienoic acid reductases (OPRs), which is one of the key synthetase genes in the biosynthesis of JA in plant [56]. The upregulation of OPR3 is also alongside the JA accumulation and the activation of the JA signal pathway [57]. The previous results of our lab showed that CsOPR3 transcription could also be upregulated by the exogenous application of JA and TG infestation, which was alongside the accumulation of JA in tea plants [39]. In A. thaliana, the expression of AtOPR3 could be induced by JA treatment and herbivore attack [58]. Given that 5b is one of the JA derivatives, we select CsOPR3 as the target gene to investigate the induction effect. As shown in the present study, 5b significantly increased the expression level of CsOPR3 in a tea plant at 1.5 h. However, due to the upregulation being at a relatively low level, it is not enough to represent that 5b could elicit the JA signaling pathway of tea plants (Figure 4). This is the first report that JA-Ile-macrolactone 5b could enhance the transcript accumulation of genes in plants. RNA-Seq analysis would be used in the following study to clarify how 5b influences the signal pathways.
Plants orchestrate appropriate defense metabolites or proteins after signaling pathways were activated. Flavonoids, nicotine, anthocyanins, benzophenanthridine alkaloids, polyphenol oxidases (PPOs), and other secondary metabolites have been reported to act as defensive components, while the content of them often influence the plants’ resistance against herbivores and pathogens [23,59]. For example, nicotine is a toxic compound stimulated by JAs in tobacco plants, which was found to inhibit the growth rate of M. sexta [60]. Other evidence showed that an artificial diet supplemented with (+)-catechin, (–)-epicatechin, epicatechin, quercetin, rhamnetin, quercetin, or rutin inhibited the larvae growth rate of the European corn borer (Pyrausta nubilalis (Hbn.)) [61]. In tea plants, caffeine was found to be one of the metabolites against anthracnose (Colletotrichum fructicola) [62]. Furthermore, the theaflavin formation from catechins is induced by tea green leafhopper attacks, while the L-theanine content is increased by tea geometrid attacks [63]. Although EDG is one of the flavonoids originally isolated from the leaves of Chrysanthemum morifolium cv., it had been reported to enhance the growth rate of cabbage looper (Trichoplusia ni) at the concentration of 10,000 ng/mL [64]. In the current study, the content of EDG in tea leaves was significantly repressed by the exogenous application of 5b (Figure 5), while the artificial diet supplemented with EDG at concentration of 2000 ng/mL significantly increased the larvae weight gain of TG (Figure 6). JA-Ile-macrolactone 5b treatment inhibited the weight gain of E. obliqua larvae through repressing the accumulation of EDG in tea leaves; thus, it is reasonable to infer that EDG probably is one of the stone components in tea plants. Not surprisingly, potato dextrose agar medium supplemented with EDG did not affect the lesions caused by C. camelliae in the testing concentration (Figure 7). Thus, other metabolites, not limited to the detected 12 flavonoids, or different concentrations of EDG, were supposed to be responsible for the inhibition of the infected of C. camelliae. Thus, although the effect of EDG on the performance of TG larvae has been evaluated indirectly, the mechanisms still need to be deeply investigated by using transcriptome and metabolome approaches.
In conclusion, the results in the present study revealed that the JA-Ile-macrolactone 5b induces the tea plant resistance to TG and C. camelliae. EDG was identified as one of the secondary metabolites that could influence the growth rate of TG, but it did not directly influence the infection of C. camelliae in vitro. Further research should be carried out to deeply elucidate the underling mechanisms.
4. Materials and Methods
4.1. Insects
E. obliqua larvae were originally captured from tea fields in Hangzhou, Zhejiang, China, and raised in the net cages (75 × 75 × 75 cm3) with potted fresh tea shoots and kept in a controlled climate room programmed at 26 ± 2 °C, 70 ± 5% RH (relative humidity), and 12 h photo phase. After one generation, E. obliqua eggs were collected and hatched in the same condition; then, the 3-day-old larvae were used for the experiments.
4.2. The Optimized Synthesis of JA-Ile-Macrolactones
All reagents were purchased from commercial sources (Aladdin Biochemical Technology Co., Ltd., Shanghai, China) and used without further purification. 1H and 13C NMR spectra were recorded at 400 MHz on Bruker spectrometer. The synthesis of JA-Ile-macrolactones was optimized based on previously described reports [33]. In the synthesis of 2, nitrogen flow was used to replace the dynamic vacuum. Hypertoxic ethyl chloroformate was changed to isobutyl chloroformate for the conjugation of 3 and L-Ile. MeCN was used to dissolve p-TsOH instead of ethyl alcohol. The NMR spectra data of all compounds were consistent with the previous report (Supplementary methods and Figure S2) [44].
4.3. Tea Plants and Treatments
Three-year-old Longjing 43 tea plants were used for the experiments, which were planted individually in plastic pots and grown in a greenhouse (26 ± 2 °C, relative humidity of 70–80%, 12 h photophase), irrigated once every other day, and fertilized with organic fertilizer once a month.
Then, 3.9 mg (12 μmol) of JA-Ile-macrolactones were dissolved into 120 μL of lanolin. The second leaf of each tea plant was smeared with 8 μL of lanolin supplemented with JA-Ile-macrolactones (0.8 µmol of each compound per leaf) and an equal amount of pure lanolin (control), respectively, and the treatments were repeated twice, 24 h apart. The treated leaves were harvested at 1.5 h, 6 h, 12 h, and 24 h after the second round of treatment. The experiment was carried out in a control climate room with the same conditions of cultivation. Each treatment replicated 6 times.
4.4. Effect of JA-Ile-Macrolactones-Treated Tea Leaves on E. obliqua Performance
Twenty-four hours after the second round of treatment, the treated leaf was covered with a fine-mesh sleeve, into which two 2nd instar E. obliqua larvae that had been starved for 6 h were introduced. After 8 days and 10 days of feeding, the larvae were weighed. During the testing process, the larvae would be transferred to another leaf of the same treatment sooner if it was almost exhausted. The experiment was replicated 22–28 times for each treatment.
4.5. Effect of JA-Ile-Macrolactones-Treated Tea Leaves on C. camelliae Infection
C. camelliae was isolated from diseased tea plants in Zhejiang (N 30°10’, E 120°5’), China and cultured on potato dextrose agar at 25 °C under 12 h photophase for 7 days. Twenty-four hours after the second round of treatment, the leaves were damaged with a sterile needle 5 times, and fungus cake (ID = 6 mm) was applied to the damaged part immediately (n = 12). After inoculation, the potted tea plants were maintained in the greenhouse, in which conditions were 26 ± 2 °C, 90 ± 5% RH (relative humidity), and 12 h photophase. Four days later, photos were taken of the infected leaves with a measuring scale, and the infection areas were calculated by adobe photoshop (Adobe Systems, San Jose, CA, USA). Twelve replications were carried out.
4.6. RNA Extraction, cDNA Synthesis, and Real-Time PCR (qPCR) Analysis
The total RNA of tea leaves was extracted via a TRIzol™ kit according to the protocol (TIANGEN, Beijing, China). Quality and concentration were examined by agarose-gel electrophoresis and spectrophotometer analysis. PrimerScript® RT Reagent Kit (Takara, Dalian, China) was used to synthesize first-strand cDNA from the total RNA following the manufacturer’s protocol. The synthesized cDNAs were stored at −20 °C for further use after reverse transcription.
The primers of all the reference genes and CsOPR3 are listed in Supplementary Table S1 according to the previous reports. The Real-Time PCR was performed on a LightCycler 480 (Roche Diagnostics, Mannheim, Germany) following the method as described by Huang [42]. The qPCR program included a preliminary step at 95 °C for 10 min, 45 cycles of a denaturation at 94 °C for 10 s, and an annealing step at 58 °C for 15 s and an extension at 72 °C for 12 s. The relative expressions were calculated by 2−∆∆Ct method.
4.7. Flavonoids Quantification
The tea leaf powders (200 mg) were extracted with 1.0 mL of 80% methanol by vortexing (2 min) and ultrasonic extraction (15 min). After centrifugation (12,000 rpm, 30 min), 500 μL of supernatant was filtered through a 0.22 μm nylon filter membrane and measured by the UPLC/MS/MS. A Waters ACQUITY UPLC H-class system (Milford, MA, USA) coupled to a Waters Xevo TQ-S Micro triple-quadrupole mass spectrometer was used for UPLC/MS/MS analysis. A Waters ACQUITY UPLC HSS T3 analytical column (1.8 μm, 2.1 mm × 100 mm) was used at a temperature of 40 °C. The sample injection volume was 5 μL. The mobile phase consisted of 0.1% (v/v) formic acid in water (A), 0.1% (v/v) formic acid in acetonitrile (B). Elution was performed in gradient mode (0 min, 95% A, and 5% B at a flow rate of 0.25 mL·min−1; 0.5 min, 85% A, and 15% B at a flow rate of 0.25 mL·min−1; 5 min, 75% A, and 25% B at a flow rate of 0.25 mL·min−1; 9 min, 35% A, and 65% at a flow rate of 0.25 mL·min−1; 9.8 min, 0% A, and 100% B at a flow rate of 0.25 mL·min−1; 10.8 min, 0% A, and 100% at a flow rate of 0.40 mL·min−1; and 11 min, 95% A, and 5% B at a flow rate of 0.40 mL·min−1). The MS/MS analysis was conducted with electrospray ionization (ESI) in positive ion mode. All the flavonoids were detected under multiple reaction monitoring (MRM) mode. The optimized MRM transitions and retention times of 12 flavonoids are shown in the Supplementary Table S2. The contents of 12 flavonoids were absolutely quantified using the calibration curves of corresponding standard solutions (Supplementary Figure S1).
4.8. In Vitro Bioassay of E. obliqua Performance and C. camelliae Infection
As the method proposed by Yang et al. [38] and Wang et al. [62], EDG were added to the artificial diets or potato dextrose agar medium for the in vitro bioassay. Artificial diets supplemented with 0 (CK), 400, and 2000 ng/mL of EDG were used for antiherbivore bioassay. Each concentration replicated 25 times. Potato dextrose agar mediums supplemented with 0 (CK) and 2000 ng/mL of EDG were used for antifungal bioassay for 5 replications.
4.9. Statistical Analysis
All statistical analyses were performed by using the Statistica (Institute Inc., Cary, NC, USA). Differences of TG larvae weight gain, infection area of C. camelliae, and qPCR analysis of CsOPR3 among treatments were analyzed via one-way ANOVA. If the ANOVA analysis was significant (p < 0.05), Tukey’s test for multiple comparisons was used to detect differences between groups. Student’s t-test was used for comparing difference between 5b treatment and control. The stability of the candidate RGs was evaluated by BestKeeper, geNorm, NormFinder, the ΔCt method, and RefFinder.
Supplementary Materials
Supplementary Materials can be found at https://www.mdpi.com/1422-0067/21/5/1828/s1.
Author Contributions
Conceptualization, S.L. and X.S.; experiments, S.L., Y.D., X.L. and M.L.; data analysis, S.L. and Y.D.; writing—original draft preparation, S.L.; writing—review and editing, X.S. and Y.X. All authors have read and agreed to the published version of the manuscript.
Funding
This research was funded by National Natural Science Foundation of China (31772180, 31972280).
Acknowledgments
We gratefully acknowledge Yuchun Wang and Fei Xiong for providing C. camelliae and Jianying Jin for rearing tea plants.
Conflicts of Interest
The authors declare no conflict of interest.
Abbreviations
| JA | Jasmonic acid |
| SA | Salicylic acid |
| ET | Ethylene |
| BTH | Benzo (1,2,3) thiadiazole-7-carbothioic acid S-methyl ester |
| INA | 2,6-Dichloroisonicotinic acid |
| BABA | β-aminobutyric acid |
| TDL | Tiadinil |
| MeJA | Methyl jasmonate |
| JAs | Jasmonates |
| JA-Ile | (+)-7-iso-Jasmonoyl-L-isoleucine |
| COI1 | CORONATINE INSENSITIVE 1 |
| JAZ | JASMONATE ZIM-DOMAIN |
| TG | Tea geometrid |
| OPR | 12-Oxophytodienoate reductase |
| HPL | hydroperoxide lyase |
| ACX | Acyl-CoA oxidase |
| PPO | polyphenol oxidase |
| LOX | lipoxygenase |
| p-TsOH | p-toluenesulfonic acid |
| MeCN | acetonitrile |
| EDG | Eriodictyol 7-O-glucuronide |
| RG | Reference Gene |
| SE | Standard Error |
| SD | Standard Deviation |
References
- Qi, J.F.; Sun, G.L.; Wang, L.; Zhao, C.X.; Hettenhausen, C.; Schuman, M.C.; Baldwin, I.T.; Li, J.; Song, J.; Liu, Z.D.; et al. Oral secretions from Mythimna separata insects specifically induce defence responses in maize as revealed by high-dimensional biological data. Plant Cell Environ. 2016, 39, 1749–1766. [Google Scholar] [CrossRef] [PubMed]
- Howe, G.A.; Jander, G. Plant immunity to insect herbivores. Annu. Rev. Plant Biol. 2008, 59, 41–66. [Google Scholar] [CrossRef] [PubMed]
- Fonseca, S.; Rosado, A.; Vaughan-Hirsch, J.; Bishopp, A.; Chini, A. Molecular locks and keys: The role of small molecules in phytohormone research. Front. Plant Sci. 2014, 5, 709. [Google Scholar] [CrossRef] [PubMed]
- Per, T.S.; Khan, M.I.R.; Anjum, N.A.; Masood, A.; Hussain, S.J.; Khan, N.A. Jasmonates in plants under abiotic stresses: Crosstalk with other phytohormones matters. Environ. Exp. Bot. 2018, 145, 104–120. [Google Scholar] [CrossRef]
- Zhou, M.; Wang, W. Recent advances in synthetic chemical inducers of plant immunity. Front. Plant Sci. 2018, 9, 1613. [Google Scholar] [CrossRef]
- Qiu, D.W.; Dong, Y.J.; Zhang, Y.; Li, S.P.; Shi, F.C. Plant immunity inducer development and application. Mol. Plant-Microbe Interact. 2017, 30, 355–360. [Google Scholar]
- Tsubata, K.; Kuroda, K.; Yamamoto, Y.; Yasokawa, N. Development of a novel plant activator for rice diseases, tiadinil. J. Pestic. Sci. 2006, 31, 161–162. [Google Scholar] [CrossRef]
- Beckers, G.J.; Conrath, U. Priming for stress resistance: From the lab to the field. Curr. Opin. Plant Biol. 2007, 10, 425–431. [Google Scholar] [CrossRef]
- Bektas, Y.; Eulgem, T. Synthetic plant defense elicitors. Front. Plant Sci. 2015, 5, 804. [Google Scholar] [CrossRef]
- Yan, J.X.; Deng, Y.A.; Yu, J.; Zhang, Y.Q.; Chi, D.F. A study on JA- and BTH-induced resistance of Rosa rugosa ‘Plena’ to powdery mildew (Sphaerotheca pannosa). J. For. Res. 2018, 29, 823–831. [Google Scholar] [CrossRef]
- Jiang, H.; Wang, B.; Ma, L.; Zheng, X.Y.; Gong, D.; Xue, H.L.; Bi, Y.; Wang, Y.; Zhang, Z.; Prusky, D. Benzo-(1,2,3)-thiadiazole-7-carbothioic acid s-methyl ester (BTH) promotes tuber wound healing of potato by elevation of phenylpropanoid metabolism. Postharvest Biol. Technol. 2019, 153, 125–132. [Google Scholar] [CrossRef]
- Qin, J.H.; Wu, M.; Liu, H.; Gao, Y.B.; Ren, A.Z. Endophyte infection and methyl jasmonate treatment increased the resistance of achnatherum sibiricum to insect herbivores independently. Toxins 2019, 11, 7. [Google Scholar] [CrossRef] [PubMed]
- Schuler, G.; Mithofer, A.; Baldwin, I.T.; Berger, S.; Ebel, J.; Santos, J.G.; Herrmann, G.; Holscher, D.; Kramell, R.; Kutchan, T.M.; et al. Coronalon: A powerful tool in plant stress physiology. FEBS Lett. 2004, 563, 17–22. [Google Scholar] [CrossRef]
- Xin, Z.J.; Chen, S.L.; Ge, L.G.; Li, X.W.; Sun, X.L. The involvement of a herbivore-induced acyl-CoA oxidase gene, CsACX1, in the synthesis of jasmonic acid and its expression in flower opening in tea plant (Camellia sinensis). Plant Physiol. Biochem. 2019, 135, 132–140. [Google Scholar] [CrossRef]
- Frew, A.; Weston, L.A.; Gurr, G.M. Silicon reduces herbivore performance via different mechanisms, depending on host-plant species. Austral Ecol. 2019, 44, 1092–1097. [Google Scholar] [CrossRef]
- Xin, Z.J.; Yu, Z.N.; Erb, M.; Turlings, T.C.J.; Wang, B.H.; Qi, J.F.; Liu, S.N.; Lou, Y.G. The broad-leaf herbicide 2,4-dichlorophenoxyacetic acid turns rice into a living trap for a major insect pest and a parasitic wasp. New Phytol. 2012, 194, 498–510. [Google Scholar] [CrossRef]
- Moraes, M.C.B.; Birkett, M.A.; Gordon-Weeks, R.; Smart, L.E.; Martin, J.L.; Pye, B.J.; Bromilow, R.; Pickett, J.A. cis-Jasmone induces accumulation of defence compounds in wheat, Triticum aestivum. Phytochemistry 2008, 69, 9–17. [Google Scholar] [CrossRef]
- Cooper, W.R.; Horton, D.R. Elicitors of host plant defenses partially suppress cacopsylla pyricola (Hemiptera: Psyllidae) Populations under Field Conditions. J. Insect Sci. 2017, 17, 2. [Google Scholar] [CrossRef]
- Bayram, A.; Tonga, A. Methyl Jasmonate Affects population densities of phytophagous and entomophagous insects in wheat. Appl. Ecol. Environ. Res. 2018, 16, 181–198. [Google Scholar] [CrossRef]
- Campos, M.L.; Kang, J.H.; Howe, G.A. Jasmonate-Triggered Plant Immunity. J. Chem. Ecol. 2014, 40, 657–675. [Google Scholar] [CrossRef]
- Wasternack, C.; Feussner, I. The oxylipin pathways: Biochemistry and function. Annu. Rev. Plant Biol. 2018, 69, 363–386. [Google Scholar] [CrossRef] [PubMed]
- Wasternack, C.; Strnad, M. Jasmonate signaling in plant stress responses and development - active and inactive compounds. N. Biotechnol. 2016, 33, 604–613. [Google Scholar] [CrossRef] [PubMed]
- Wasternack, C.; Strnad, M. Jasmonates are signals in the biosynthesis of secondary metabolites - Pathways, transcription factors and applied aspects—A brief review. N. Biotechnol. 2019, 48, 1–11. [Google Scholar] [CrossRef]
- Sheard, L.B.; Tan, X.; Mao, H.B.; Withers, J.; Ben-Nissan, G.; Hinds, T.R.; Kobayashi, Y.; Hsu, F.F.; Sharon, M.; Browse, J.; et al. Jasmonate perception by inositol-phosphate-potentiated COI1-JAZ co-receptor. Nature 2010, 468, 400–405. [Google Scholar] [CrossRef]
- Rohwer, C.L.; Erwin, J.E. Horticultural applications of jasmonates: A review. J. Horticult. Sci. Biotechnol. 2008, 83, 283–304. [Google Scholar] [CrossRef]
- Cui, J.; Bahrami, A.K.; Pringle, E.G.; Hernandez-Guzman, G.; Bender, C.L.; Pierce, N.E.; Ausubel, F.M. Pseudomonas syringae manipulates systemic plant defenses against pathogens and herbivores. Proc. Natl. Acad. Sci. USA 2005, 102, 1791–1796. [Google Scholar] [CrossRef]
- Pieterse, C.M.J.; van Wees, S.C.M.; van Pelt, J.A.; Knoester, M.; Laan, R.; Gerrits, N.; Weisbeek, P.J.; van Loon, L.C. A novel signaling pathway controlling induced systemic resistance in Arabidopsis. Plant Cell 1998, 10, 1571–1580. [Google Scholar] [CrossRef]
- Svoboda, J.; Boland, W. Plant defense elicitors: Analogues of jasmonoyl-isoleucine conjugate. Phytochemistry 2010, 71, 1445–1449. [Google Scholar] [CrossRef]
- Yan, J.B.; Li, S.H.; Gu, M.; Yao, R.; Li, Y.W.; Chen, J.; Yang, M.; Tong, J.H.; Xiao, L.T.; Nan, F.J.; et al. Endogenous bioactive jasmonate is composed of a set of (+)-7-iso-JA- amino acid conjugates. Plant Physiol. 2016, 172, 2154–2164. [Google Scholar] [CrossRef]
- Ichihara, A.; Shiraishi, K.; Sato, H.; Sakamura, S.; Nishiyama, K.; Sakai, R.; Furusaki, A.; Matsumoto, T. The structure of coronatine. J. Am. Chem. Soc. 1977, 99, 636–637. [Google Scholar] [CrossRef]
- Ballare, C.L.; Austin, A.T. Recalculating growth and defense strategies under competition: Key roles of photoreceptors and jasmonates. J. Exp. Bot. 2019, 70, 3425–3434. [Google Scholar] [CrossRef]
- Jimenez-Aleman, G.H.; Machado, R.A.R.; Gorls, H.; Baldwin, I.T.; Boland, W. Synthesis, structural characterization and biological activity of two diastereomeric JA-Ile macrolactones. Org. Biomol. Chem. 2015, 13, 5885–5893. [Google Scholar] [CrossRef]
- Jimenez-Aleman, G.H.; Machado, R.A.R.; Baldwin, I.T.; Boland, W. JA-Ile-macrolactones uncouple growth and defense in wild tobacco. Org. Biomol. Chem. 2017, 15, 3391–3395. [Google Scholar] [CrossRef]
- Burketova, L.; Trda, L.; Ott, P.G.; Valentova, O. Bio-based resistance inducers for sustainable plant protection against pathogens. Biotechnol. Adv. 2015, 33, 994–1004. [Google Scholar] [CrossRef]
- Wang, D.; Li, C.F.; Ma, C.L.; Chen, L. Novel insights into the molecular mechanisms underlying the resistance of Camellia sinensis to Ectropis oblique provided by strategic transcriptomic comparisons. Sci. Hortic. 2015, 192, 429–440. [Google Scholar] [CrossRef]
- Zeng, W.A.; Zhou, G.S.; Deng, Z.P.; Kuan, C.F. Biological control progress of Ectropis Obliqua Prout. Tea Comm. 2008, 35, 30–32. [Google Scholar]
- Wang, Y.; Hao, X.; Huang, Y.; Yue, C.; Wang, B.; Cao, H.; Wang, L.; Wang, X.; Yang, Y.; Xiao, B. Phylogenetic study of colletotrichum species associated with Camellia sinensis from the major tea areas in China. Sci. Agri. Sin. 2015, 48, 4924–4935. [Google Scholar]
- Yang, Z.W.; Duan, X.N.; Jin, S.; Li, X.W.; Chen, Z.M.; Ren, B.Z.; Sun, X.L. Regurgitant derived from the tea geometrid Ectropis obliqua suppresses wound-induced polyphenol oxidases activity in tea plants. J. Chem. Ecol. 2013, 39, 744–751. [Google Scholar] [CrossRef]
- Xin, Z.J.; Zhang, J.; Ge, L.G.; Lei, S.; Han, J.J.; Zhang, X.; Li, X.W.; Sun, X.L. A putative 12-oxophytodienoate reductase gene CsOPR3 from Camellia sinensis, is involved in wound and herbivore infestation responses. Gene 2017, 615, 18–24. [Google Scholar] [CrossRef]
- Xin, Z.J.; Zhang, L.P.; Zhang, Z.Q.; Chen, Z.M.; Sun, X.L. A tea hydroperoxide lyase gene, CsiHPL1, regulates tomato defense response against Prodenia Litura (Fabricius) and Alternaria Alternata f. sp Lycopersici by modulating green leaf volatiles (GLVs) release and jasmonic acid (JA) gene expression. Plant Mol. Biol. Rep. 2014, 32, 62–69. [Google Scholar] [CrossRef]
- Huang, C.; Zhang, J.; Zhang, X.; Yu, Y.C.; Bian, W.B.; Zeng, Z.P.; Sun, X.L.; Li, X.H. Two new polyphenol oxidase genes of tea plant (Camellia sinensis) respond differentially to the regurgitant of tea geometrid, Ectropis obliqua. Int. J. Mol. Sci. 2018, 19, 2414. [Google Scholar] [CrossRef]
- Li, X.; Ahammed, G.J.; Li, Z.X.; Tang, M.J.; Yan, P.; Han, W.Y. Decreased biosynthesis of jasmonic acid via lipoxygenase pathway compromised caffeine-induced resistance to Colletotrichum gloeosporioides under elevated CO2 in tea seedlings. Phytopathology 2016, 106, 1270–1277. [Google Scholar] [CrossRef]
- Zhang, J.; Zhang, X.; Ye, M.; Li, X.W.; Lin, S.B.; Sun, X.L. The jasmonic acid pathway positively regulates the polyphenol oxidase-based defense against tea geometrid caterpillars in the tea plant (Camellia sinensis). J. Chem. Ecol. 2020. [Google Scholar] [CrossRef]
- Jimenez-Aleman, G.H.; Secinti, S.; Boland, W. A succinct access to omega-hydroxylated jasmonates via olefin metathesis. Z. Naturforsch. C. 2017, 72, 285–292. [Google Scholar] [CrossRef]
- Hao, X.Y.; Horvath, D.P.; Chao, W.S.; Yang, Y.J.; Wang, X.C.; Xiao, B. Identification and evaluation of reliable reference genes for quantitative Real-Time PCR analysis in tea Plant (Camellia sinensis (L.) O. Kuntze). Int. J. Mol. Sci. 2014, 15, 22155–22172. [Google Scholar] [CrossRef]
- Ma, Q.P.; Hao, S.; Chen, X.; Li, X.H. Validation of reliability for reference genes under various abiotic stresses in tea plant. Russ. J. Plant. Physl. 2016, 63, 423–432. [Google Scholar] [CrossRef]
- Wu, Z.J.; Tian, C.; Jiang, Q.; Li, X.H.; Zhuang, J. Selection of suitable reference genes for qRT-PCR normalization during leaf development and hormonal stimuli in tea plant (Camellia sinensis). Sci. Rep. 2016, 6, 19748. [Google Scholar] [CrossRef]
- Wang, M.L.; Li, Q.H.; Xin, H.H.; Chen, X.; Zhu, X.J.; Li, X.H. Reliable reference genes for normalization of gene expression data in tea plants (Camellia sinensis) exposed to metal stresses. Plos ONE 2017, 12, 4. [Google Scholar] [CrossRef]
- Vandesompele, J.; De Preter, K.; Pattyn, F.; Poppe, B.; Van Roy, N.; De Paepe, A.; Speleman, F. Accurate normalization of real-time quantitative RT-PCR data by geometric averaging of multiple internal control genes. Genome Biol. 2002, 3, 7. [Google Scholar] [CrossRef]
- Andersen, C.L.; Jensen, J.L.; Orntoft, T.F. Normalization of real-time quantitative reverse transcription-PCR data: A model-based variance estimation approach to identify genes suited for normalization, applied to bladder and colon cancer data sets. Cancer Res. 2004, 64, 5245–5250. [Google Scholar] [CrossRef]
- Pfaffl, M.W.; Tichopad, A.; Prgomet, C.; Neuvians, T.P. Determination of stable housekeeping genes, differentially regulated target genes and sample integrity: BestKeeper - Excel-based tool using pair-wise correlations. Biotechnol. Lett. 2004, 26, 509–515. [Google Scholar] [CrossRef] [PubMed]
- He, X.R.; Yu, Z.N.; Jiang, S.J.; Zhang, P.Z.; Shang, Z.C.; Lou, Y.G.; Wu, J. Finding new elicitors that induce resistance in rice to the white-backed planthopper Sogatella furcifera. Bioorg. Med. Chem. Lett. 2015, 25, 5601–5603. [Google Scholar] [CrossRef] [PubMed]
- Pare, P.W.; Farag, M.A.; Krishnamachari, V.; Zhang, H.M.; Ryu, C.M.; Kloepper, J.W. Elicitors and priming agents initiate plant defense responses. Photosynth. Res. 2005, 85, 149–159. [Google Scholar] [CrossRef] [PubMed]
- Terry, L.A.; Joyce, D.C. Elicitors of induced disease resistance in postharvest horticultural crops: A brief review. Postharvest Biol. Technol. 2004, 32, 1–13. [Google Scholar] [CrossRef]
- Xin, Z.J.; Li, X.W.; Li, J.C.; Chen, Z.M.; Sun, X.L. Application of chemical elicitor (Z)-3-hexenol enhances direct and indirect plant defenses against tea geometrid Ectropis obliqua. BioControl 2016, 61, 1–12. [Google Scholar] [CrossRef]
- Schaller, F.; Biesgen, C.; Mussig, C.; Altmann, T.; Weiler, E.W. 12-oxophytodienoate reductase 3 (OPR3) is the isoenzyme involved in jasmonate biosynthesis. Planta 2000, 210, 979–984. [Google Scholar] [CrossRef]
- Browse, J. Jasmonate Passes Muster: A receptor and targets for the defense hormone. Annu. Rev. Plant Biol. 2009, 60, 183–205. [Google Scholar] [CrossRef]
- Mussig, C.; Biesgen, C.; Lisso, J.; Uwer, U.; Weiler, E.W.; Altmann, T. A novel stress-inducible 12-oxophytodienoate reductase from Arabidopsis thaliana provides a potential link between Brassinosteroid-action and Jasmonic-acid synthesis. J. Plant Physiol. 2000, 157, 143–152. [Google Scholar] [CrossRef]
- Giri, C.C.; Zaheer, M. Chemical elicitors versus secondary metabolite production in vitro using plant cell, tissue and organ cultures: Recent trends and a sky eye view appraisal. Plant Cell Tiss. Org. 2016, 126, 1–18. [Google Scholar] [CrossRef]
- Baldwin, I.T. Inducible nicotine production in native Nicotiana as an example of adaptive phenotypic plasticity. J. Chem. Ecol. 1999, 25, 3–30. [Google Scholar] [CrossRef]
- Abou-Zaid, M.M.; Beninger, C.W.; Arnason, J.T.; Nozzolillo, C. The effect of one flavone, two catechins and four flavonols on mortality and growth of the European corn borer (Ostrinia nubilalis Hubner). Biochem. Syst. Ecol. 1993, 21, 415–420. [Google Scholar] [CrossRef]
- Wang, Y.C.; Qian, W.J.; Li, N.N.; Hao, X.Y.; Wang, L.; Xiao, B.; Wang, X.C.; Yang, Y.J. Metabolic changes of caffeine in tea plant (Camellia sinensis (L.) O. Kuntze) as defense response to Colletotrichum fructicola. J. Agric. Food. Chem. 2016, 64, 6685–6693. [Google Scholar] [CrossRef]
- Liao, Y.Y.; Yu, Z.M.; Liu, X.Y.; Zeng, L.T.; Cheng, S.H.; Li, J.L.; Tang, J.C.; Yang, Z.Y. Effect of major tea insect attack on formation of quality-related nonvolatile specialized metabolites in tea (Camellia sinensis) leaves. J. Agric. Food. Chem. 2019, 67, 6716–6724. [Google Scholar] [CrossRef]
- Beninger, C.W.; Abou-Zaid, M.M.; Kistner, A.L.E.; Hallett, R.H.; Iqbal, M.J.; Grodzinski, B.; Hall, J.C. A flavanone and two phenolic acids from Chrysanthemum morifolium with phytotoxic and insect growth regulating activity. J. Chem. Ecol. 2004, 30, 589–606. [Google Scholar] [CrossRef]
© 2020 by the authors. Licensee MDPI, Basel, Switzerland. This article is an open access article distributed under the terms and conditions of the Creative Commons Attribution (CC BY) license (http://creativecommons.org/licenses/by/4.0/).








